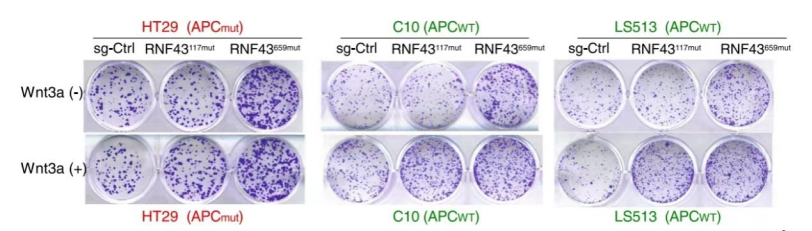
image.png

04
2022-08
Citation 導(dǎo)言 結(jié)直腸癌(CRC)是第三大常見癌癥,占全球所有新癌癥病例的10%,是全球癌癥相關(guān)死亡的第二大原因,導(dǎo)致2020年近100萬(wàn)人死亡,且年輕者發(fā)病率不斷上升[1,2]。在中國(guó),結(jié)直腸癌的新發(fā)病人數(shù)僅次于肺癌,成為第二大癌癥,據(jù)最新數(shù)據(jù),我國(guó)83%的結(jié)直腸癌患者在首次確診時(shí)處于中晚期,其中44%的患者已經(jīng)出現(xiàn)了肝、肺等部位的轉(zhuǎn)移。盡管當(dāng)前結(jié)直腸癌的治療策略有了進(jìn)步,但結(jié)直腸癌患者的預(yù)后僅略有改善,而開發(fā)新治療方法PI3K/mTOR抑制劑對(duì)攜帶RNF43 p.G659fs突變的結(jié)直腸癌患者是否具有治療應(yīng)用價(jià)值亟待對(duì)疾病機(jī)制的了進(jìn)一步了解,確定關(guān)鍵基因變異的特定功能對(duì)于促進(jìn)新的靶向治療方法至關(guān)重要,并最終改善患者的預(yù)后。
研究背景
RNF43基因(Ring Finger Protein 43)編碼一種環(huán)型E3泛素連接酶,它作為Wnt信號(hào)通路的負(fù)調(diào)節(jié)因子主要是通過降解Wnt受體Frizzled來(lái)實(shí)現(xiàn)。因此,RNF43功能的喪失將導(dǎo)致腫瘤細(xì)胞依賴分泌的Wnt配體來(lái)存活[3-5]。 RNF43是CRC和其他惡性腫瘤中經(jīng)常發(fā)生突變的基因,且RNF43 p.G659fs突變?cè)诩s8%的CRC患者中出現(xiàn),尤其是在DNA錯(cuò)配修復(fù)缺陷(dMMR)/高微衛(wèi)星不穩(wěn)定性(MSI-H)的患者中更常見[6],但其作為熱點(diǎn)突變的功能影響還有待進(jìn)一步研究,且也沒有針對(duì)的特定療法,探索其中機(jī)制對(duì)新療法開發(fā)至關(guān)重要。 本文小編將帶大家一起看看這篇刊登于Nature Communications的文章:RNF43 G659fs is an oncogenic colorectal cancer mutation and sensitizes tumor cells to PI3K/mTOR inhibition(譯名:結(jié)直腸癌致突變RNF43 G659fs可使腫瘤細(xì)胞對(duì)PI3K/mTOR抑制劑敏感),從機(jī)制上探索PI3K/mTOR抑制劑對(duì)攜帶RNF43 p.G659fs突變的結(jié)直腸癌患者是否具有治療應(yīng)用價(jià)值。
研究背景
RNF43659mut具有不依賴Wnt的致癌作用 為研究RNF43上兩個(gè)熱點(diǎn)移碼突變(p.R117fs和 p.G659fs)的功能。經(jīng)過CRISPR-Cas9編輯構(gòu)建的RNF43117mut和RNF43659mut等基因細(xì)胞系。在培養(yǎng)之初加入Wnt-3a,結(jié)果顯示,與對(duì)照組相比,RNF43117mut組在加入Wnt-3a后生長(zhǎng)顯著加速。而RNF43659mut組沒有明顯差別(圖1)。且RNF43659mut組增加了三個(gè)株系聚落形成(圖1),而這些聚落的形成與Wnt-3a和APC無(wú)關(guān)。表明了RNF43117mut的功能是Wnt依賴性的,而RNF43659mut不是。為了進(jìn)一步驗(yàn)證結(jié)果,使用TOP/FOP熒光素酶報(bào)告分析測(cè)量Wnt信號(hào)活性。發(fā)現(xiàn)補(bǔ)充Wnt-3a的RNF43117mut組顯著增加Wnt信號(hào)。與對(duì)照組相比,RNF43659mut組Wnt信號(hào)未顯著增加(圖2) 圖1 圖2 (注:熒光素酶報(bào)告物測(cè)定所示CRISPR編輯細(xì)胞中的Wnt信號(hào)活性) RNF43659mut激活PI3K/AKT信號(hào)通路,易受PI3K/mTOR抑制劑的影響 為了發(fā)現(xiàn)RNF43659mut CRC細(xì)胞潛在的治療藥物,對(duì)RNF43659mutCRC細(xì)胞進(jìn)行了全面的藥篩。在5363種處于臨床前和臨床開發(fā)不同階段的化合物列表中,分別篩選出了30種和22種PI3K/mTOR途徑的藥物。與二甲基亞砜處理和等基因?qū)φ障啾?,該途徑在選擇性靶向RNF43659mut的重組文庫(kù)化合物中顯著富集(圖3)。發(fā)現(xiàn)五種化合物alpelisib,PF-04691502,PKI-179,Torin-1和Torin-2,在RNF43659mut等基因細(xì)胞系中表現(xiàn)出顯著的選擇性殺傷效果(圖4,6)。此外,對(duì)RNF43 p.G659fs 過表達(dá)細(xì)胞中使用五種化合物的劑量-反應(yīng)曲線中,五種化合物對(duì)RNF43659mut細(xì)胞和過表達(dá)RNF43659mut細(xì)胞顯示出有效和選擇性毒性,但對(duì)sgRNA對(duì)照細(xì)胞或野生型過表達(dá)細(xì)胞沒有毒性(圖5)。這些結(jié)果共同證明了RNF43659mut激活PI3K/AKT信號(hào),PI3K/mTOR抑制劑可以靶向殺傷RNF43659mut突變的腫瘤。 圖3 圖4 圖5 Venn圖顯示HT29、LS513 RNF43659mut編輯細(xì)胞和HCT116 RNF43659mut過度表達(dá)細(xì)胞中PI3K/mTOR顯著候選化合物重疊(紅色),其中n為在每個(gè)細(xì)胞系的二次篩選中驗(yàn)證的主篩選中的化合物數(shù)量 圖6 CRC RNF43 G659fs臨床前模型中PI3K/mTOR復(fù)合效率的評(píng)估 RNF43659mut通過RNF43659mut-p85相互作用激活PI3K/AKT信號(hào) 研究發(fā)現(xiàn)RNF43 p.G659fs突變?cè)隗w外和體內(nèi)激活PI3K,并表明這種激活是通過降解PI3K調(diào)節(jié)亞基p85發(fā)生的。在突變體中,RNF43 p.G659fs通過結(jié)合降解p85來(lái)消除p85對(duì)PI3K/AKT信號(hào)的抑制,從而激活PI3K/AKT信號(hào),加快癌細(xì)胞的生長(zhǎng),并且RNF43 p.G659fs誘導(dǎo)的PI3K/AKT信號(hào)激活可以被PI3K/mTOR抑制劑逆轉(zhuǎn)。這也進(jìn)一步證明PI3K/mTOR抑制劑能通過直接抑制PI3K/AKT信號(hào),從而抑制攜帶RNF43 p.G659fs突變腫瘤細(xì)胞的生長(zhǎng)。 圖7 泛素免疫沉淀分析評(píng)估觀察到RNF43659mut增加了P85的泛素化 RNF43659mut調(diào)節(jié)干擾素基因表達(dá) 研究對(duì)RNF43659mut等基因細(xì)胞系的RNA測(cè)序揭示了降低干擾素-α和-γ反應(yīng)的基因表達(dá),這些基因集分別有助于炎癥反應(yīng)和先天性免疫反應(yīng),且這種降低的活性可以被PI3K/mTOR抑制劑恢復(fù),這說明RNF43659mut可能改變腫瘤免疫環(huán)境。

研究結(jié)論
本研究證明了RNF43 p.G659fs突變具有不依賴Wnt的致癌作用,RNF43 p.G659fs與p85亞基結(jié)合降解,消除p85對(duì)PI3K/AKT信號(hào)通路的抑制作用,可導(dǎo)致PI3K信號(hào)增強(qiáng),因而PI3K/mTOR抑制劑可以逆轉(zhuǎn)p.G659fs誘導(dǎo)的PI3K/AKT信號(hào)通路的激活,它可對(duì)攜帶該突變的結(jié)直腸腫瘤選擇性殺傷。驗(yàn)證了PI3K/mTOR抑制劑在治療RNF43 p.G659fs突變型癌癥中具有應(yīng)用價(jià)值,另外基于RNF43659mut調(diào)節(jié)干擾素基因表達(dá),也提出了將免疫治療和PI3K/mTOR抑制劑結(jié)合進(jìn)行治療的可能性,尤其是治療失敗的DNA錯(cuò)配修復(fù)缺陷(dMMR)/高微衛(wèi)星不穩(wěn)定性(MSI-H)結(jié)直腸癌患者。因此對(duì)RNF43 p.G659fs突變型結(jié)直腸癌的研究發(fā)現(xiàn)為未來(lái)治療新方法的開發(fā)拓展了新視野。
研究啟示
文中建立了CRC患者來(lái)源的類器官,腫瘤組織取自患者來(lái)源的RNF43_G659fs異種移植模型。同時(shí)也建立正常的患者來(lái)源的結(jié)腸類器官。應(yīng)用類器官進(jìn)行藥物處理,驗(yàn)證了PI3K/mTOR抑制劑在RNF43659mut等基因細(xì)胞系和異種移植模型(PDX),以及在患者來(lái)源的含有RNF43 p G659fs突變的類器官中都產(chǎn)生了良好的抗腫瘤活性。 作者之所以如此選擇,因?yàn)椴煌哪P投加衅渥陨淼木窒扌?,?xì)胞系包含的細(xì)胞類型過于單一,喪失了腫瘤的異質(zhì)性。而人源腫瘤異種移植模型,不僅存在人鼠之間物種的差異,而且成本高昂、建模周期長(zhǎng)和建模成功率低,也無(wú)法高通量使用等問題。相比來(lái)說,類器官具有擬合度高、培養(yǎng)周期短、傳代穩(wěn)定、易自動(dòng)化等優(yōu)勢(shì),具備了高通量使用的條件。 類器官技術(shù)是科技部發(fā)布了“十四五”國(guó)家重點(diǎn)研發(fā)計(jì)劃的6個(gè)重點(diǎn)專項(xiàng)之一,由于類器官技術(shù)本身具有極高的創(chuàng)新性,類器官已成為疾病研究、新藥開發(fā)領(lǐng)域最受矚目的模型,深受基金項(xiàng)目申請(qǐng)和高分雜志的青睞,使用類器官發(fā)表文章及申請(qǐng)國(guó)自然都是很有優(yōu)勢(shì)的。 廣州精科醫(yī)學(xué)檢驗(yàn)所有限公司 廣州精科醫(yī)學(xué)檢驗(yàn)所有限公司是精科生物集團(tuán)旗下的全資子公司,是一家以類器官技術(shù)+基因組學(xué)技術(shù)為雙驅(qū)核心的第三方醫(yī)學(xué)檢驗(yàn)所。公司在類器官方向致力于推動(dòng)類器官技術(shù)的轉(zhuǎn)化與應(yīng)用,在科研上打造全面的類器官技術(shù)服務(wù)體系,而在臨床上提供高效的類器官+NGS的綜合檢測(cè)服務(wù)。 ★ PIC.08 精科腸癌類器官 HE圖片 參考文獻(xiàn) [1]Siegel, R. L., Miller, K. D. & Jemal, A. Cancer statistics, 2020. CA Cancer J. Clin. 70, 7–30 (2020). [2]Cancer Genome Atlas Network. Comprehensive molecular characterization of human colon and rectal cancer. Nature 487, 330–337 (2013). [3]Wong, C. C. et al. SLC25A22 promotes proliferation and survival of colorectal cancer cells with KRAS mutations and xenograft tumor progression in mice via intracellular synthesis of aspartate. Gastroenterology 151, 945–960 (2016). [4]Liu, X. et al. Inhibition of PCSK9 potentiates immune checkpoint therapy for cancer. Nature 588, 693–698 (2020). [5]Roig, A. I. et al. Immortalized epithelial cells derived from human colon biopsies express stem cell markers and differentiate in vitro. Gastroenterology 138, 1012–1021 (2010). [6]Zhang, L. et al. Selective targeting of mutant adenomatous polyposis coli (APC) in colorectal cancer. Sci. Transl. Med. 8, 361ra140 (2016).